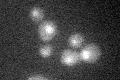
YLR015W
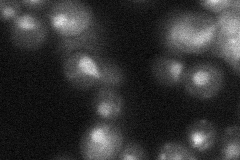
YLR015W

View description
Subunit of COMPASS (Set1C) complex, which methylates Lys4 of histone H3 and functions in silencing at telomeres; has a C-terminal Sdc1 Dpy-30 Interaction (SDI) domain that mediates binding to Sdc1p; similar to trithorax-group protein ASH2L
Localization:
Intensity:
Fold change:
Significance:
-
C’ GFP library in SD
nucleus19.95 -
N' NOP1pr-GFP in SD

nucleus57.6682 -
N' TEF2pr-mCherry in SD

punctate,nucleus26.5521 -
N' NATIVEpr-GFP in SD
nucleus32.8698 -
N' TEF2pr-VC and Cyto-VN in SD

#N/A0 -
C’ GFP library in SD+DTT

nucleus19.590.98No -
C’ GFP library in SD+H2O2

nucleus17.960.9No -
C’ GFP library in Starvation Media

nucleus16.560.83No -
C’ GFP library on the background of Pup2-DaMP

nucleus -
C’ GFP library on the background of CCT mutant

nucleus23.44871.17515No
